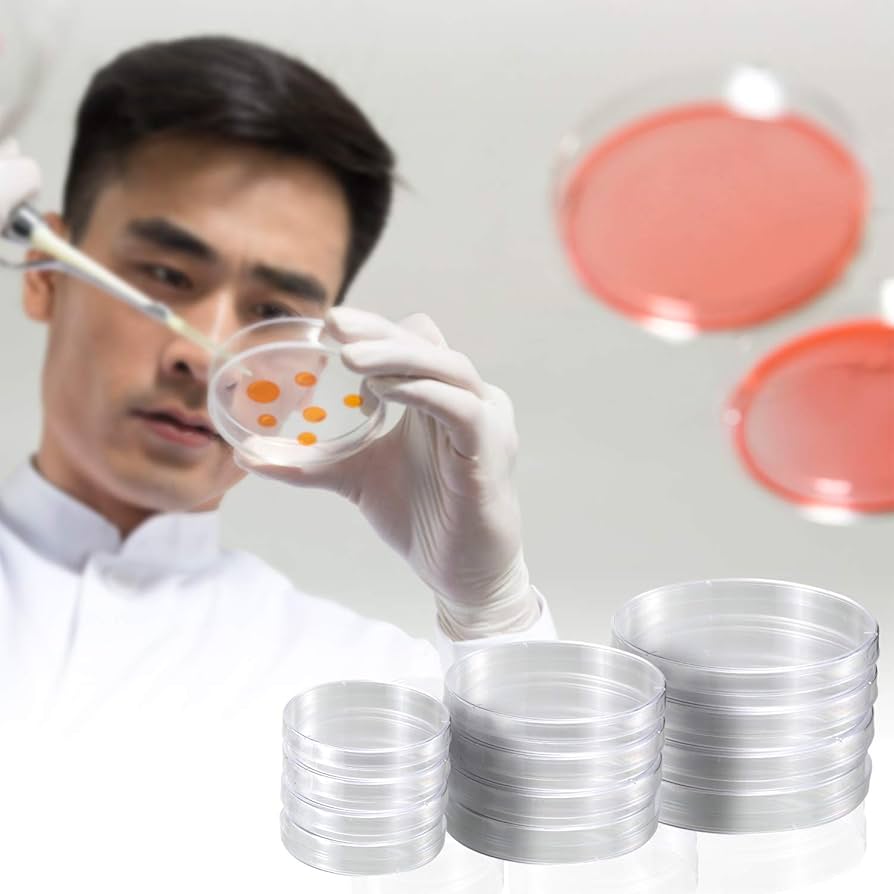
Petree Dishes DELSEN 30 Pcs Petri Dish Set 70+55+30 Mm Petri Dishes With Lids Sterile Plastic Petri Dishes Comes With 5 Plastic Transfer Pipettes For 4oz Plastic Containers With Lids

More delivery methods in checkout
Return this item within 7 days of purchase.
Get an immediate answer with AI
AI-generated from the text of manufacturer documentation. To verify or get additional information, please contact customer service.
4.4 out of 5